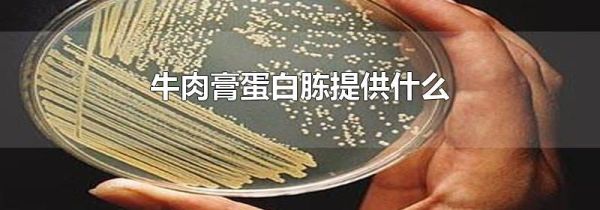
牛肉膏蛋白胨提供什么

牛肉膏蛋白胨主要提供碳源,氮源,磷酸盐,维生素和无机盐。牛肉膏蛋白胨是一种琼脂培养基,因为价格相对便宜又容易制作,在微生物培养中有着广泛的应用。
牛肉膏蛋白胨提供什么
由于不同的微生物需要的营养不同,一种培养基不可能适合所有微生物,但牛肉膏蛋白胨培养基提供的营养是大部分微生物都需要的。
牛肉膏蛋白胨培养基在制作与使用过程中需要注意规范使用,防止细菌污染,否则会使培养基失去营养。
在牛肉膏蛋白胨培养基制作过程中可以加入其他营养物质来制成不同的培养基,用来培养不同的微生物。

牛肉膏蛋白胨主要提供碳源,氮源,磷酸盐,维生素和无机盐。牛肉膏蛋白胨是一种琼脂培养基,因为价格相对便宜又容易制作,在微生物培养中有着广泛的应用。
牛肉膏蛋白胨提供什么
由于不同的微生物需要的营养不同,一种培养基不可能适合所有微生物,但牛肉膏蛋白胨培养基提供的营养是大部分微生物都需要的。
牛肉膏蛋白胨培养基在制作与使用过程中需要注意规范使用,防止细菌污染,否则会使培养基失去营养。
在牛肉膏蛋白胨培养基制作过程中可以加入其他营养物质来制成不同的培养基,用来培养不同的微生物。
相关文章:1. 神舟十一号降落地点2. 夏天火车上有空调吗3. 煤是岩石还是矿物4. 六月开什么花5. 新疆小白杏可以放冰箱吗6. 清凉油涂哪里提神醒脑7. 蜂蜜夏天冒泡起沫是怎么回事8. 大熊猫的爱好9. 从中国到美国坐飞机要多久时间10. 沈阳美食

网公网安备:皖ICP备2020019022号-8 Copyright ¢ 2020-2025 Powered by V1.8 All Rights Reserved 技术支持:乐呵呵网
声明:本站所有资源以学习为主
